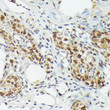
Immunohistochemistry analysis of MT2A in paraffin-embedded rat ovary using MT2A Rabbit polyclonal antibody (STJ24624) at dilution of 1:100 (40x lens). Perform high pressure antigen retrieval with 10 mM citrate buffer pH 6. 0 before commencing with immunohistochemistry staining protocol.

| Host: | Rabbit |
| Applications: | WB/IHC-P/ELISA |
| Reactivity: | Human/Mouse/Rat |
| Note: | STRICTLY FOR FURTHER SCIENTIFIC RESEARCH USE ONLY (RUO). MUST NOT TO BE USED IN DIAGNOSTIC OR THERAPEUTIC APPLICATIONS. |
| Clonality : | Polyclonal |
| Conjugation: | Unconjugated |
| Isotype: | IgG |
| Formulation: | PBS with 0.09% Sodium Azide, 50% Glycerol, pH 7.3. |
| Purification: | Affinity purification |
| Concentration: | Lot specific |
| Dilution Range: | WB:1:500-1:2000IHC-P:1:50-1:200ELISA:Recommended starting concentration is 1 Mu g/mL. Please optimize the concentration based on your specific assay requirements. |
| Storage Instruction: | Store at-20°C for up to 1 year from the date of receipt, and avoid repeat freeze-thaw cycles. |
| Gene Symbol: | MT2A |
| Gene ID: | 4502 |
| Uniprot ID: | MT2_HUMAN |
| Immunogen Region: | 1-61 |
| Specificity: | Recombinant fusion protein containing a sequence corresponding to amino acids 1-61 of human MT2A (NP_005944.1). |
| Immunogen Sequence: | MDPNCSCAAGDSCTCAGSCK CKECKCTSCKKSCCSCCPVG CAKCAQGCICKGASDKCSCC A |
| Function | Metallothioneins have a high content of cysteine residues that bind various heavy metals.these proteins are transcriptionally regulated by both heavy metals and glucocorticoids. |
| Protein Name | Metallothionein-2Mt-2Metallothionein-2aMetallothionein-IiMt-Ii |
| Database Links | Reactome: R-HSA-5661231Reactome: R-HSA-877300 |
| Alternative Antibody Names | Anti-Metallothionein-2 antibodyAnti-Mt-2 antibodyAnti-Metallothionein-2a antibodyAnti-Metallothionein-Ii antibodyAnti-Mt-Ii antibodyAnti-MT2A antibodyAnti-CES1 antibodyAnti-MT2 antibody |
Information sourced from Uniprot.org